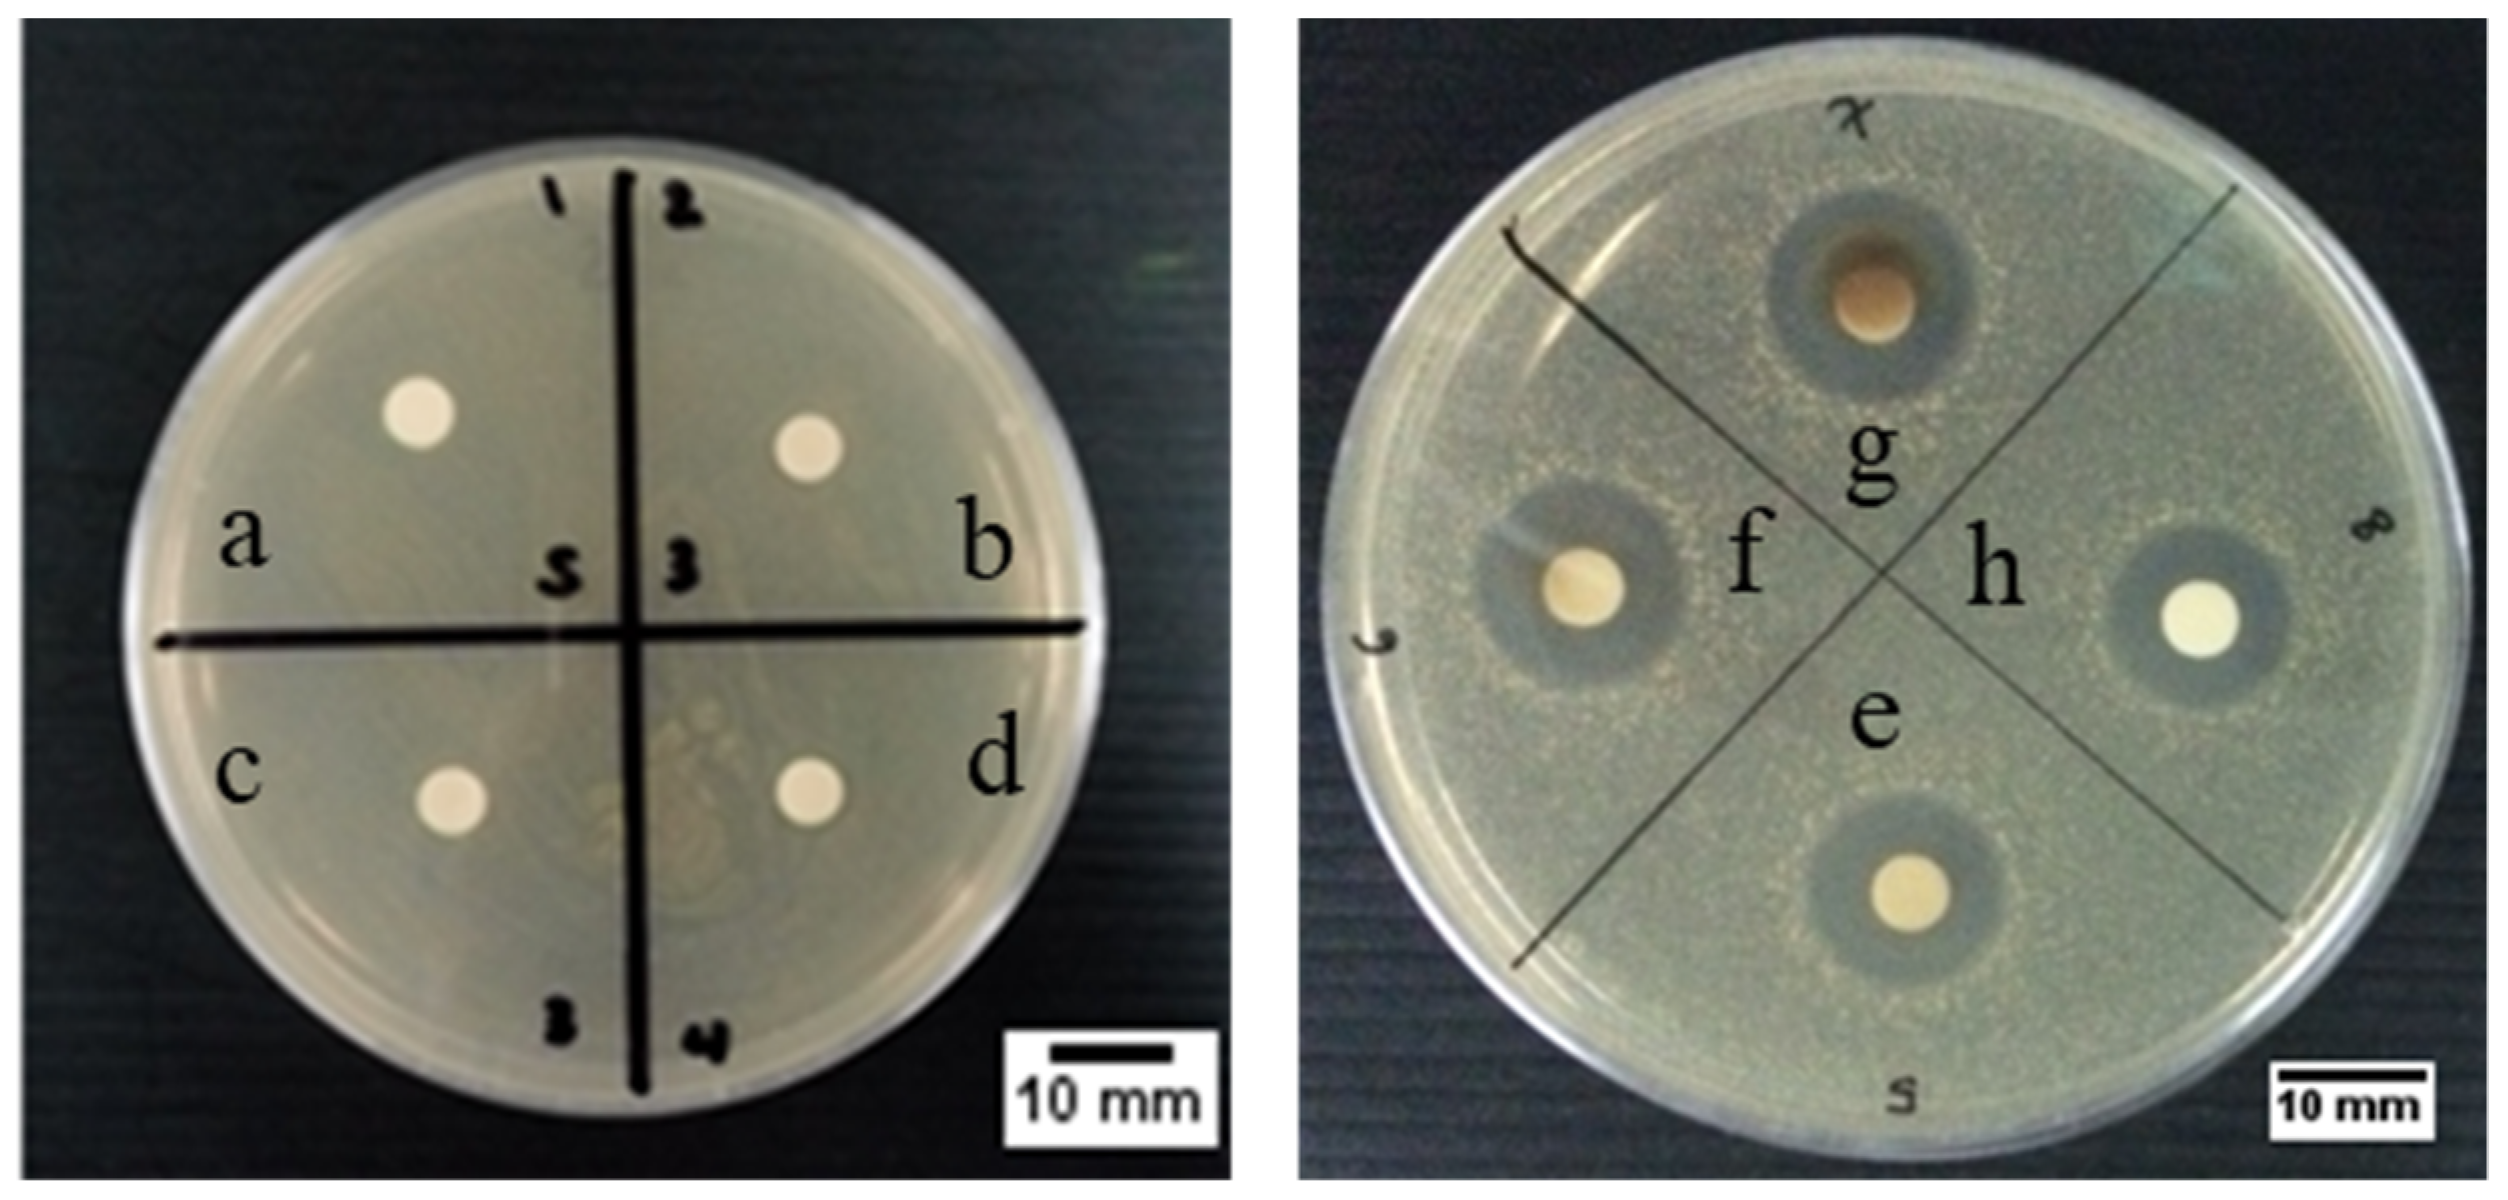
Molecules 26 02042 g008 Molecules 26 02042 g008

Green Synthesis of Silver Nanoparticles Using Extract of Cilembu Sweet Potatoes (Ipomoea batatas L var. Rancing) as Potential Filler for 3D Printed Electroactive and Anti-Infection Scaffolds
Abstract
1. Introduction
2. Results and Discussion
2.1. Green Synthesis of AgNPs
2.1.1. Visual Observation and UV-Vis Spectroscopy Results
2.1.2. X-ray Diffraction (XRD) Results
2.1.3. Dynamic Light Scattering (DLS) and Zeta Potential Results
2.1.4. Transmission Electron Microscopy (TEM) Results
2.1.5. Fourier Transform Infrared (FTIR) Results
2.1.6. Antibacterial Properties
2.2. Fabrication of 3D Printed Scaffold
2.2.1. Scaffold Morphology and Porosity
2.2.2. Wettability
2.2.3. Mechanical Properties
2.2.4. Conductivity
2.2.5. Antibacterial Properties
2.3. AgNPs Production and Scaffold Fabrication Discussion
3. Materials and Methods
3.1. Materials
3.2. Preparation and Characterization of Silver Nanoparticles
3.2.1. Preparation of Extract of Cilembu Sweet Potatoes
3.2.2. Synthesis of Silver Nanoparticles
3.2.3. Silver Nanoparticles Characterization
UV-Vis Spectroscopy
X-ray Diffraction
Ion Chromatography
Dynamic Light Scattering and Zeta Potential
Transmission Electron Microscopy and Selected Area Electron Diffraction
Fourier Transmitted Infra-Red Spectroscopy
The Disc Diffusion Test
3.3. Fabrication and Characterization of 3D Printed of PCL/AgNPs Scaffold
3.3.1. Fabrication of PCL/AgNPs Scaffolds
3.3.2. Scaffold Characterization
Morphology
Wettability
Mechanical Properties
Electrical Conductivity
Total Plate Count Method
4. Conclusions
Author Contributions
Funding
Institutional Review Board Statement
Informed Consent Statement
Data Availability Statement
Acknowledgments
Conflicts of Interest
Sample Availability
References
- Zhang, Z.; Klausen, L.H.; Chen, M.; Dong, M. Electroactive Scaffolds for Neurogenesis and Myogenesis: Graphene-Based Nanomaterials. Small 2018, 14, 1801983. [Google Scholar] [CrossRef]
- Thrivikraman, G.; Boda, S.K.; Basu, B. Unraveling the mechanistic effects of electric field stimulation towards directing stem cell fate and function: A tissue engineering perspective. Biomaterials 2018, 150, 60–86. [Google Scholar] [CrossRef]
- Wang, W.; Hou, Y.; Martinez, D.; Kurniawan, D.; Chiang, W.-H.; Bartolo, P. Carbon Nanomaterials for Electro-Active Structures: A Review. Polymers 2020, 12, 2946. [Google Scholar] [CrossRef]
- Leppik, L.; Zhihua, H.; Mobini, S.; Parameswaran, V.T.; Eischen-Loges, M.; Slavici, A.; Helbing, J.; Pindur, L.; Oliveira, K.M.; Bhavsar, M.B. Combining electrical stimulation and tissue engineering to treat large bone defects in a rat model. Sci. Rep. 2018, 8, 6307. [Google Scholar] [CrossRef]
- Ezazi, N.Z.; Shahbazi, M.-A.; Shatalin, Y.V.; Nadal, E.; Mäkilä, E.; Salonen, J.; Kemell, M.; Correia, A.; Hirvonen, J.; Santos, H.A. Conductive vancomycin-loaded mesoporous silica polypyrrole-based scaffolds for bone regeneration. Int. J. Pharm. 2018, 536, 241–250. [Google Scholar] [CrossRef]
- Wibowo, A.; Vyas, C.; Cooper, G.; Qulub, F.; Suratman, R.; Mahyuddin, A.I.; Dirgantara, T.; Bartolo, P. 3D printing of polycaprolactone—Polyaniline electroactive scaffolds for bone tissue engineering. Materials 2020, 13, 512. [Google Scholar] [CrossRef]
- Wang, S.; Guan, S.; Xu, J.; Li, W.; Ge, D.; Sun, C.; Liu, T.; Ma, X. Neural stem cell proliferation and differentiation in the conductive PEDOT-HA/Cs/Gel scaffold for neural tissue engineering. Biomater. Sci. 2017, 5, 2024–2034. [Google Scholar] [CrossRef]
- Vohrer, U.; Kolaric, I.; Haque, M.; Roth, S.; Detlaff-Weglikowska, U. Carbon nanotube sheets for the use as artificial muscles. Carbon 2004, 42, 1159–1164. [Google Scholar] [CrossRef]
- Spearman, B.S.; Hodge, A.J.; Porter, J.L.; Hardy, J.G.; Davis, Z.D.; Xu, T.; Zhang, X.; Schmidt, C.E.; Hamilton, M.C.; Lipke, E.A. Conductive interpenetrating networks of polypyrrole and polycaprolactone encourage electrophysiological development of cardiac cells. Acta Biomater. 2015, 28, 109–120. [Google Scholar] [CrossRef] [PubMed]
- Fleischer, S.; Shevach, M.; Feiner, R.; Dvir, T. Coiled fiber scaffolds embedded with gold nanoparticles improve the performance of engineered cardiac tissues. Nanoscale 2014, 6, 9410–9414. [Google Scholar] [CrossRef] [PubMed]
- Palza, H.; Zapata, P.A.; Angulo-Pineda, C. Electroactive smart polymers for biomedical applications. Materials 2019, 12, 277. [Google Scholar] [CrossRef]
- Chen, J.; Yu, M.; Guo, B.; Ma, P.X.; Yin, Z. Conductive nanofibrous composite scaffolds based on in-situ formed polyaniline nanoparticle and polylactide for bone regeneration. J. Colloid Interface Sci. 2018, 514, 517–527. [Google Scholar] [CrossRef]
- Liu, C.; Chan, K.W.; Shen, J.; Wong, H.M.; Yeung, K.W.K.; Tjong, S.C. Melt-compounded polylactic acid composite hybrids with hydroxyapatite nanorods and silver nanoparticles: Biodegradation, antibacterial ability, bioactivity and cytotoxicity. RSC Adv. 2015, 5, 72288–72299. [Google Scholar] [CrossRef]
- Slepička, P.; Michaljaničová, I.; Kasálková, N.S.; Kolská, Z.; Rimpelová, S.; Ruml, T.; Švorčík, V. Poly-l-lactic acid modified by etching and grafting with gold nanoparticles. J. Mater. Sci. 2013, 48, 5871–5879. [Google Scholar] [CrossRef]
- Rimpelová, S.; Peterková, L.; Kasálková, N.S.; Slepička, P.; Švorčík, V.; Ruml, T. Surface Modification of Biodegradable Poly(L-Lactic Acid) by Argon Plasma: Fibroblasts and Keratinocytes in the Spotlight. Plasma Process. Polym. 2014, 11, 1057–1067. [Google Scholar] [CrossRef]
- Li, J.; Ma, P.C.; Chow, W.S.; To, C.K.; Tang, B.Z.; Kim, J.K. Correlations between percolation threshold, dispersion state, and aspect ratio of carbon nanotubes. Adv. Funct. Mater. 2007, 17, 3207–3215. [Google Scholar] [CrossRef]
- Huang, B.; Vyas, C.; Roberts, I.; Poutrel, Q.-A.; Chiang, W.-H.; Blaker, J.J.; Huang, Z.; Bártolo, P. Fabrication and characterisation of 3D printed MWCNT composite porous scaffolds for bone regeneration. Mater. Sci. Eng. C 2019, 98, 266–278. [Google Scholar] [CrossRef] [PubMed]
- Stewart, I.E.; Kim, M.J.; Wiley, B.J. Effect of morphology on the electrical resistivity of silver nanostructure films. ACS Appl. Mater. Interfaces 2017, 9, 1870–1876. [Google Scholar] [CrossRef] [PubMed]
- Xu, L.; Wang, Y.-Y.; Huang, J.; Chen, C.-Y.; Wang, Z.-X.; Xie, H. Silver nanoparticles: Synthesis, medical applications and biosafety. Theranostics 2020, 10, 8996. [Google Scholar] [CrossRef]
- Qing, T.; Mahmood, M.; Zheng, Y.; Biris, A.S.; Shi, L.; Casciano, D.A. A genomic characterization of the influence of silver nanoparticles on bone differentiation in MC3T3-E1 cells. J. Appl. Toxicol. 2018, 38, 172–179. [Google Scholar] [CrossRef] [PubMed]
- Zhang, R.; Lee, P.; Lui, V.C.; Chen, Y.; Liu, X.; Lok, C.N.; To, M.; Yeung, K.W.; Wong, K.K. Silver nanoparticles promote osteogenesis of mesenchymal stem cells and improve bone fracture healing in osteogenesis mechanism mouse model. Nanomed. Nanotechnol. Biol. Med. 2015, 11, 1949–1959. [Google Scholar] [CrossRef]
- Hileuskaya, K.; Ladutska, A.; Kulikouskaya, V.; Kraskouski, A.; Novik, G.; Kozerozhets, I.; Kozlovskiy, A.; Agabekov, V. ‘Green’ approach for obtaining stable pectin-capped silver nanoparticles: Physico-chemical characterization and antibacterial activity. Colloids Surf. A Physicochem. Eng. Asp. 2020, 585, 124141. [Google Scholar] [CrossRef]
- Rai, M.K.; Deshmukh, S.; Ingle, A.; Gade, A. Silver nanoparticles: The powerful nanoweapon against multidrug-resistant bacteria. J. Appl. Microbiol. 2012, 112, 841–852. [Google Scholar] [CrossRef] [PubMed]
- Zeng, S.; Baillargeat, D.; Ho, H.-P.; Yong, K.-T. Nanomaterials enhanced surface plasmon resonance for biological and chemical sensing applications. Chem. Soc. Rev. 2014, 43, 3426–3452. [Google Scholar] [CrossRef] [PubMed]
- Gallo, J.; Panacek, A.; Prucek, R.; Kriegova, E.; Hradilova, S.; Hobza, M.; Holinka, M. Silver nanocoating technology in the prevention of prosthetic joint infection. Materials 2016, 9, 337. [Google Scholar] [CrossRef]
- Li, T.-T.; Lou, C.-W.; Chen, A.-P.; Lee, M.-C.; Ho, T.-F.; Chen, Y.-S.; Lin, J.-H. Highly absorbent antibacterial hemostatic dressing for healing severe hemorrhagic wounds. Materials 2016, 9, 793. [Google Scholar] [CrossRef]
- Ohashi, S.; Saku, S.; Yamamoto, K. Antibacterial activity of silver inorganic agent YDA filler. J. Oral Rehabil. 2004, 31, 364–367. [Google Scholar] [CrossRef]
- Rónavári, A.; Igaz, N.; Adamecz, D.I.; Szerencsés, B.; Molnar, C.; Kónya, Z.; Pfeiffer, I.; Kiricsi, M. Green Silver and Gold Nanoparticles: Biological Synthesis Approaches and Potentials for Biomedical Applications. Molecules 2021, 26, 844. [Google Scholar] [CrossRef]
- Kolarova, K.; Vosmanská, V.; Rimpelová, S.; Ulbrich, P.; Svorcik, V. Silver nanoparticles stabilized using chitosan films: Preparation, properties and antibacterial activity. J. Nanosci. Nanotechnol. 2015, 15, 10120–10126. [Google Scholar] [CrossRef]
- Kaabipour, S.; Hemmati, S. A review on the green and sustainable synthesis of silver nanoparticles and one-dimensional silver nanostructures. Beilstein J. Nanotechnol. 2021, 12, 102–136. [Google Scholar] [CrossRef]
- Siegel, J.; Kolářová, K.; Vosmanská, V.; Rimpelová, S.; Leitner, J.; Švorčík, V. Antibacterial properties of green-synthesized noble metal nanoparticles. Mater. Lett. 2013, 113, 59–62. [Google Scholar] [CrossRef]
- Padnya, P.; Gorbachuk, V.; Stoikov, I. The Role of Calix [n] arenes and Pillar [n] arenes in the Design of Silver Nanoparticles: Self-Assembly and Application. Int. J. Mol. Sci. 2020, 21, 1425. [Google Scholar] [CrossRef] [PubMed]
- Okaiyeto, K.; Ojemaye, M.O.; Hoppe, H.; Mabinya, L.V.; Okoh, A.I. Phytofabrication of silver/silver chloride nanoparticles using aqueous leaf extract of oedera genistifolia: Characterization and antibacterial potential. Molecules 2019, 24, 4382. [Google Scholar] [CrossRef] [PubMed]
- Ahmadi, O.; Jafarizadeh-Malmiri, H.; Jodeiri, N. Eco-friendly microwave-enhanced green synthesis of silver nanoparticles using Aloe vera leaf extract and their physico-chemical and antibacterial studies. Green Process. Synth. 2018, 7, 231–240. [Google Scholar] [CrossRef]
- Sathyavathi, R.; Krishna, M.B.; Rao, S.V.; Saritha, R.; Rao, D.N. Biosynthesis of silver nanoparticles using Coriandrum sativum leaf extract and their application in nonlinear optics. Adv. Sci. Lett. 2010, 3, 138–143. [Google Scholar] [CrossRef]
- Hamouda, R.A.; Hussein, M.H.; Abo-elmagd, R.A.; Bawazir, S.S. Synthesis and biological characterization of silver nanoparticles derived from the cyanobacterium Oscillatoria limnetica. Sci. Rep. 2019, 9, 13071. [Google Scholar] [CrossRef]
- Elamawi, R.M.; Al-Harbi, R.E.; Hendi, A.A. Biosynthesis and characterization of silver nanoparticles using Trichoderma longibrachiatum and their effect on phytopathogenic fungi. Egypt. J. Biol. Pest Control 2018, 28, 28. [Google Scholar] [CrossRef]
- Roy, S.; Das, T.K. Plant mediated green synthesis of silver nanoparticles-A. Int. J. Plant Biol. Res. 2015, 3, 1044–1055. [Google Scholar]
- Rumbaoa, R.G.O.; Cornago, D.F.; Geronimo, I.M. Phenolic content and antioxidant capacity of Philippine sweet potato (Ipomoea batatas) varieties. Food Chem. 2009, 113, 1133–1138. [Google Scholar] [CrossRef]
- Wu, X.; Sun, C.; Yang, L.; Zeng, G.; Liu, Z.; Li, Y. β-carotene content in sweet potato varieties from China and the effect of preparation on β-carotene retention in the Yanshu No. 5. Innov. Food Sci. Emerg. Technol. 2008, 9, 581–586. [Google Scholar] [CrossRef]
- Truong, V.D.; McFeeters, R.; Thompson, R.; Dean, L.; Shofran, B. Phenolic acid content and composition in leaves and roots of common commercial sweetpotato (Ipomea batatas L.) cultivars in the United States. J. Food Sci. 2007, 72, C343–C349. [Google Scholar] [CrossRef] [PubMed]
- Nayem, S.; Sultana, N.; Haque, M.; Miah, B.; Hasan, M.; Islam, T.; Awal, A.; Uddin, J.; Aziz, M.; Ahammad, A. Green Synthesis of Gold and Silver Nanoparticles by Using Amorphophallus paeoniifolius Tuber Extract and Evaluation of Their Antibacterial Activity. Molecules 2020, 25, 4773. [Google Scholar] [CrossRef]
- Lai, Y.-C.; Huang, C.-L.; Chan, C.-F.; Lien, C.-Y.; Liao, W.C. Studies of sugar composition and starch morphology of baked sweet potatoes (Ipomoea batatas (L.) Lam). J. Food Sci. Technol. 2013, 50, 1193–1199. [Google Scholar] [CrossRef]
- Taufik, I.I.; Guntarti, A. Comparison of reduction sugar analysis method in cilembu sweet potato (Ipomoea batatas L.) using luff schoorl and anthrone method. J. Kedokt. Kesehat. Indones. 2016, 7, 219–226. [Google Scholar] [CrossRef]
- Khlebtsov, N.G.; Dykman, L.A. Optical properties and biomedical applications of plasmonic nanoparticles. J. Quant. Spectrosc. Radiat. Transf. 2010, 111, 1–35. [Google Scholar] [CrossRef]
- Zhu, Y.; Liu, H.; Yang, L.; Liu, J. Study on the synthesis of Ag/AgCl nanoparticles and their photocatalytic properties. Mater. Res. Bull. 2012, 47, 3452–3458. [Google Scholar] [CrossRef]
- Khan, Z.; Singh, T.; Hussain, J.I.; Obaid, A.Y.; AL-Thabaiti, S.A.; El-Mossalamy, E. Starch-directed green synthesis, characterization and morphology of silver nanoparticles. Colloids Surf. B Biointerfaces 2013, 102, 578–584. [Google Scholar] [CrossRef]
- Shannon, R.D. Revised effective ionic radii and systematic studies of interatomic distances in halides and chalcogenides. Acta Crystallogr. Sect. A Cryst. Phys. Diffr. Theor. Gen. Crystallogr. 1976, 32, 751–767. [Google Scholar] [CrossRef]
- Raut, R.W.; Mendhulkar, V.D.; Kashid, S.B. Photosensitized synthesis of silver nanoparticles using Withania somnifera leaf powder and silver nitrate. J. Photochem. Photobiol. B Biol. 2014, 132, 45–55. [Google Scholar] [CrossRef]
- Roy, K.; Sarkar, C.; Ghosh, C. Photocatalytic activity of biogenic silver nanoparticles synthesized using potato (Solanum tuberosum) infusion. Spectrochim. Acta Part A Mol. Biomol. Spectrosc. 2015, 146, 286–291. [Google Scholar] [CrossRef] [PubMed]
- Dos Santos, M.A.; Paterno, L.G.; Moreira, S.G.C.; Sales, M.J.A. Original photochemical synthesis of Ag nanoparticles mediated by potato starch. SN Appl. Sci. 2019, 1, 554. [Google Scholar] [CrossRef]
- Tomaszewska, E.; Soliwoda, K.; Kadziola, K.; Tkacz-Szczesna, B.; Celichowski, G.; Cichomski, M.; Szmaja, W.; Grobelny, J. Detection limits of DLS and UV-Vis spectroscopy in characterization of polydisperse nanoparticles colloids. J. Nanomater. 2013, 2013, 313081. [Google Scholar] [CrossRef]
- Patterson, J.P.; Sanchez, A.M.; Petzetakis, N.; Smart, T.P.; Epps, T.H., III; Portman, I.; Wilson, N.R.; O’Reilly, R.K. A simple approach to characterizing block copolymer assemblies: Graphene oxide supports for high contrast multi-technique imaging. Soft Matter 2012, 8, 3322–3328. [Google Scholar] [CrossRef] [PubMed]
- Hong, X.; Wen, J.; Xiong, X.; Hu, Y. Shape effect on the antibacterial activity of silver nanoparticles synthesized via a microwave-assisted method. Environ. Sci. Pollut. Res. 2016, 23, 4489–4497. [Google Scholar] [CrossRef]
- Smith, B.C. Infrared Spectral Interpretation: A Systematic Approach; CRC Press: Boca Raton, FL, USA, 2018. [Google Scholar]
- Cruz, D.; Falé, P.L.; Mourato, A.; Vaz, P.D.; Serralheiro, M.L.; Lino, A.R.L. Preparation and physicochemical characterization of Ag nanoparticles biosynthesized by Lippia citriodora (Lemon Verbena). Colloids Surf. B Biointerfaces 2010, 81, 67–73. [Google Scholar] [CrossRef] [PubMed]
- Mendoza-Reséndez, R.; Núñez, N.O.; Barriga-Castro, E.D.; Luna, C. Synthesis of metallic silver nanoparticles and silver organometallic nanodisks mediated by extracts of Capsicum annuum var. aviculare (piquin) fruits. RSC Adv. 2013, 3, 20765–20771. [Google Scholar] [CrossRef]
- Campoccia, D.; Montanaro, L.; Arciola, C.R. The significance of infection related to orthopedic devices and issues of antibiotic resistance. Biomaterials 2006, 27, 2331–2339. [Google Scholar] [CrossRef]
- Ribeiro, M.; Monteiro, F.J.; Ferraz, M.P. Infection of orthopedic implants with emphasis on bacterial adhesion process and techniques used in studying bacterial-material interactions. Biomatter 2012, 2, 176–194. [Google Scholar] [CrossRef]
- Lyutakov, O.; Goncharova, I.; Rimpelova, S.; Kolarova, K.; Svanda, J.; Svorcik, V. Silver release and antimicrobial properties of PMMA films doped with silver ions, nano-particles and complexes. Mater. Sci. Eng. C 2015, 49, 534–540. [Google Scholar] [CrossRef]
- Liu, F.; Wang, W.; Mirihanage, W.; Hinduja, S.; Bartolo, P. A plasma-assisted bioextrusion system for tissue engineering. CIRP Ann. 2018, 67, 229–232. [Google Scholar] [CrossRef]
- International Organization for Standardization. Rigid Cellular Plastics-Determination of Compression Properties; ISO: Geneva, Switzerland, 2014. [Google Scholar]
- Fortunati, E.; D’angelo, F.; Martino, S.; Orlacchio, A.; Kenny, J.; Armentano, I. Carbon nanotubes and silver nanoparticles for multifunctional conductive biopolymer composites. Carbon 2011, 49, 2370–2379. [Google Scholar] [CrossRef]
- Vaidhyanathan, B.; Vincent, P.; Vadivel, S.; Karuppiah, P.; AL-Dhabi, N.A.; Sadhasivam, D.R.; Vimalraj, S.; Saravanan, S. Fabrication and Investigation of the Suitability of Chitosan-Silver Composite Scaffolds for Bone Tissue Engineering Applications. Process Biochem. 2020, 100, 178–187. [Google Scholar] [CrossRef]
- Bandyopadhyay, A.; Espana, F.; Balla, V.K.; Bose, S.; Ohgami, Y.; Davies, N.M. Influence of porosity on mechanical properties and in vivo response of Ti6Al4V implants. Acta Biomater. 2010, 6, 1640–1648. [Google Scholar] [CrossRef] [PubMed]
- Oftadeh, R.; Perez-Viloria, M.; Villa-Camacho, J.C.; Vaziri, A.; Nazarian, A. Biomechanics and mechanobiology of trabecular bone: A review. J. Biomech. Eng. 2015, 137, 010802. [Google Scholar] [CrossRef] [PubMed]
- Wu, J.C.-C.; Ray, S.; Gizdavic-Nikolaidis, M.; Uy, B.; Swift, S.; Jin, J.; Cooney, R.P. Nanostructured bioactive material based on polycaprolactone and polyaniline fiber-scaffolds. Synth. Met. 2014, 198, 41–50. [Google Scholar] [CrossRef]
- Saha, S.; Williams, P.A. Comparison of the electrical and dielectric behavior of wet human cortical and cancellous bone tissue from the distal tibia. J. Orthop. Res. 1995, 13, 524–532. [Google Scholar] [CrossRef]
- Radhakrishnan, S.; Nagarajan, S.; Belaid, H.; Farha, C.; Iatsunskyi, I.; Coy, E.; Soussan, L.; Huon, V.; Bares, J.; Belkacemi, K. Fabrication of 3D printed antimicrobial polycaprolactone scaffolds for tissue engineering applications. Mater. Sci. Eng. C 2021, 118, 111525. [Google Scholar] [CrossRef] [PubMed]
- Gao, Y.; Hassanbhai, A.M.; Lim, J.; Wang, L.; Xu, C. Fabrication of a silver octahedral nanoparticle-containing polycaprolactone nanocomposite for antibacterial bone scaffolds. RSC Adv. 2017, 7, 10051–10056. [Google Scholar] [CrossRef]
- De Matteis, V.; Cascione, M.; Toma, C.C.; Leporatti, S. Silver nanoparticles: Synthetic routes, in vitro toxicity and theranostic applications for cancer disease. Nanomaterials 2018, 8, 319. [Google Scholar] [CrossRef] [PubMed]
- Velmurugan, P.; Anbalagan, K.; Manosathyadevan, M.; Lee, K.-J.; Cho, M.; Lee, S.-M.; Park, J.-H.; Oh, S.-G.; Bang, K.-S.; Oh, B.-T. Green synthesis of silver and gold nanoparticles using Zingiber officinale root extract and antibacterial activity of silver nanoparticles against food pathogens. Bioprocess Biosyst. Eng. 2014, 37, 1935–1943. [Google Scholar] [CrossRef]
- Hudzicki, J. Kirby-Bauer Disk Diffusion Susceptibility Test Protocol; American Society for Microbiology: Washington, DC, USA, 2009; pp. 1–23. Available online: https://www.asmscience.org/content/education/protocol/protocol.3189 (accessed on 26 February 2021).
- Othman, M.; San Loh, H.; Wiart, C.; Khoo, T.J.; Lim, K.H.; Ting, K.N. Optimal methods for evaluating antimicrobial activities from plant extracts. J. Microbiol. Methods 2011, 84, 161–166. [Google Scholar] [CrossRef] [PubMed]
- Loh, Q.L.; Choong, C. Three-dimensional scaffolds for tissue engineering applications: Role of porosity and pore size. Tissue Eng. Part B Rev. 2013, 19, 485–502. [Google Scholar] [CrossRef] [PubMed]
- Chen, M.-C.; Sun, Y.-C.; Chen, Y.-H. Electrically conductive nanofibers with highly oriented structures and their potential application in skeletal muscle tissue engineering. Acta Biomater. 2013, 9, 5562–5572. [Google Scholar] [CrossRef] [PubMed]
- Dai, Z.; Ronholm, J.; Tian, Y.; Sethi, B.; Cao, X. Sterilization techniques for biodegradable scaffolds in tissue engineering applications. J. Tissue Eng. 2016, 7, 2041731416648810. [Google Scholar] [CrossRef]

| Sample Code | DLS Results | Zeta Potential (mV) | |
|---|---|---|---|
| Average Diameter (nm) | Polydispersity Index | ||
| Baked 1 | 364.6 ± 95.3 | 0.25 ± 0.04 | −15.5 ± 2.0 |
| Baked 10 | 105.5 ± 12.6 | 0.29 ± 0.02 | −41.0 ± 9.0 |
| Baked 100 | 456.5 ± 14.7 | 0.22 ± 0.01 | −0.7 ± 0.4 |
| Unbaked 10 | 5958.8 ± 499.6 | 0.29 ± 0.02 | −0.3 ± 0.1 |
| Sample | Sample Form | ZOI (mm) |
|---|---|---|
| Extract-only | Liquid | 0 |
| Baked 1 | Powder | 0 |
| Baked 10 | 0 | |
| Baked 100 | 0 | |
| Baked 1 | Colloidal | 11.2 ± 0.3 |
| Baked 10 | 12.9 ± 0.3 | |
| Baked 100 | 15.1 ± 0.6 | |
| Unbaked 10 | 11.7 ± 0.3 |
| Scaffold Sample | Fiber Diameter (µm) | Pore Size (µm) | Porosity (%) |
|---|---|---|---|
| PCL | 480 ± 76 | 569 ± 59 | 70 ± 34 |
| PCL/AgNPs | 536 ± 24 | 425 ± 39 | 60 ± 4 |
| Scaffold Sample | Compressive Young’s Modulus (MPa) | Compressive Strength (MPa) |
|---|---|---|
| PCL | 13.65 ± 2.17 | 0.65 ± 0.09 |
| PCL/AgNPs | 52.42 ± 7.64 | 3.88 ± 0.42 |
Publisher’s Note: MDPI stays neutral with regard to jurisdictional claims in published maps and institutional affiliations. |
© 2021 by the authors. Licensee MDPI, Basel, Switzerland. This article is an open access article distributed under the terms and conditions of the Creative Commons Attribution (CC BY) license (https://creativecommons.org/licenses/by/4.0/).
Share and Cite
Wibowo, A.; Tajalla, G.U.N.; Marsudi, M.A.; Cooper, G.; Asri, L.A.T.W.; Liu, F.; Ardy, H.; Bartolo, P.J.D.S. Green Synthesis of Silver Nanoparticles Using Extract of Cilembu Sweet Potatoes (Ipomoea batatas L var. Rancing) as Potential Filler for 3D Printed Electroactive and Anti-Infection Scaffolds. Molecules 2021, 26, 2042. https://doi.org/10.3390/molecules26072042
Wibowo A, Tajalla GUN, Marsudi MA, Cooper G, Asri LATW, Liu F, Ardy H, Bartolo PJDS. Green Synthesis of Silver Nanoparticles Using Extract of Cilembu Sweet Potatoes (Ipomoea batatas L var. Rancing) as Potential Filler for 3D Printed Electroactive and Anti-Infection Scaffolds. Molecules. 2021; 26(7):2042. https://doi.org/10.3390/molecules26072042
Chicago/Turabian StyleWibowo, Arie, Gusti U. N. Tajalla, Maradhana A. Marsudi, Glen Cooper, Lia A.T.W. Asri, Fengyuan Liu, Husaini Ardy, and Paulo J.D.S. Bartolo. 2021. "Green Synthesis of Silver Nanoparticles Using Extract of Cilembu Sweet Potatoes (Ipomoea batatas L var. Rancing) as Potential Filler for 3D Printed Electroactive and Anti-Infection Scaffolds" Molecules 26, no. 7: 2042. https://doi.org/10.3390/molecules26072042
APA StyleWibowo, A., Tajalla, G. U. N., Marsudi, M. A., Cooper, G., Asri, L. A. T. W., Liu, F., Ardy, H., & Bartolo, P. J. D. S. (2021). Green Synthesis of Silver Nanoparticles Using Extract of Cilembu Sweet Potatoes (Ipomoea batatas L var. Rancing) as Potential Filler for 3D Printed Electroactive and Anti-Infection Scaffolds. Molecules, 26(7), 2042. https://doi.org/10.3390/molecules26072042

